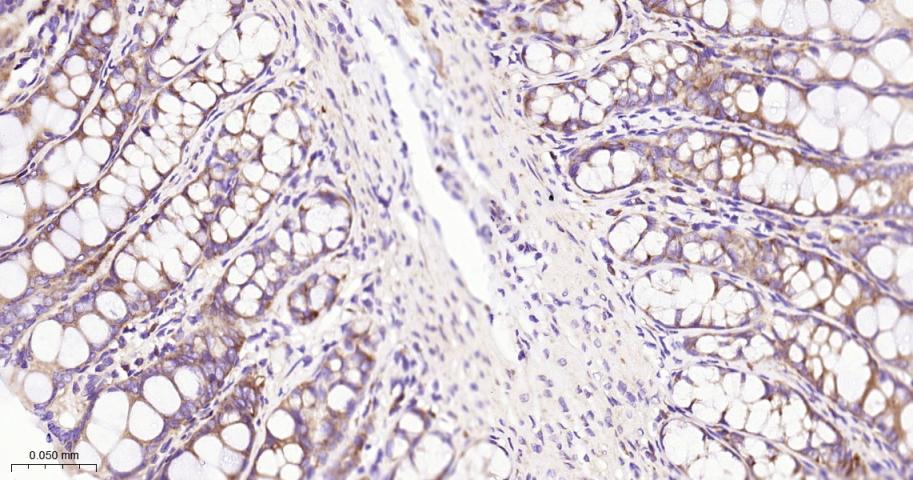
真核启动因子2α(eIFα2)兔单克隆抗体

真核启动因子2α(eIFα2)兔单克隆抗体
Rrmab?兔单抗

货号:bsm-60003R
产品详情
相关标记
相关产品
相关文献
常见问题
概述
产品编号
bsm-60003R
产品类型
重组兔单抗、mIHC精品抗体
英文名称
EIF2S1 Recombinant Rabbit mAb
中文名称
真核启动因子2α(eIFα2)兔单克隆抗体
英文别名
IF2A_HUMAN; EIF2S1; Eukaryotic translation initiation factor 2 subunit alpha (eIF-2-alpha | eIF-2A | eIF-2alpha | eIF2-alpha); EIF2A; IF2A_MOUSE; IF2A_RAT;
抗体来源
Rabbit
免疫原
KLH conjugated synthetic peptide derived from human EIF2S1
亚型
IgG
性状
Liquid
纯化方法
affinity purified by Protein A
克隆类型
Recombinant
克隆号
5A1
理论分子量
36 kDa
浓度
1mg/ml
储存液
0.01M TBS (pH7.4) with 1% BSA, 0.02% Proclin300 and 50% Glycerol.
研究领域
SWISS
Gene ID
保存条件
Shipped at 4℃. Store at -20℃ for one year. Avoid repeated freeze/thaw cycles.
注意事项
This product as supplied is intended for research use only, not for use in human, therapeutic or diagnostic applications.
数据库链接
产品介绍
eIF2α(真核启动因子2α)
背景资料
eIF2 alpha is a 36 kDa protein which is ubiquitously expressed in many cell types. The eIF2 protein, which is composed of three subunits (alpha, beta and gamma), is one of the key molecules in the initiation of translation. In mammalian cells, eIF2 alpha is phosphorylated at serine 51 (human EIF2 alpha, the equivalent residue in mouse is serine 52) by at least two kinases: the haem-controlled repressor (HCR) and the interferon inducible double stranded RNA-dependent protein kinase (PKR). Phosphorylation of eIF2 alpha blocks the GDP-GTP exchange activity of eIF2 beta, resulting in the suppression of protein synthesis. The phosphorylation of eIF2 alpha is an important regulatory process in protein synthesis.

产品应用
| 应用 | 已检合格种属 | 预测种属 | 推荐稀释比例 |
|---|---|---|---|
| WB | Human, Mouse, Rat | 1:500-2000 | |
| IHC-P | Human, Mouse, Rat | 1:200-1000 | |
| IHC-F | Human, Mouse, Rat | 1:200-1000 | |
| IF | Human, Mouse, Rat | 1:200-1000 |
交叉反应
交叉反应: Human, Mouse, Rat
相关产品
暂无相关产品
靶标
基因名
EIF2S1
蛋白名
Eukaryotic translation initiation factor 2 subunit 1
亚基
Heterotrimer composed of an alpha, a beta and a gamma chain. Component of an EIF2 complex at least composed of CELF1/CUGBP1, CALR, CALR3, EIF2S1, EIF2S2, HSP90B1 and HSPA5. Interaction with METAP2 protects EIF2S1 from inhibitory phosphorylation. Interacts with ABCF1 isoform 2. Associates with ribosomes.
亚细胞定位
Cytoplasmic granule. Note=The cytoplasmic granules are stress granules which are a dense aggregation in the cytosol composed of proteins and RNAs that appear when the cell is under stress. Co-localizes with NANOS3 in the stress granules.
翻译后修饰
Substrate for at least 4 kinases: EIF2AK3/PERK, GCN2, HRI and PKR. Phosphorylation stabilizes the eIF-2/GDP/eIF-2B complex and prevents GDP/GTP exchange reaction, thus impairing the recycling of eIF-2 between successive rounds of initiation and leading to global inhibition of translation. In case of infection by vaccinia virus or rotavirus A, eIF2S1 phosphorylation state is modulated.
相似性
Belongs to the eIF-2-alpha family.
Contains 1 S1 motif domain.
Contains 1 S1 motif domain.
功能
Functions in the early steps of protein synthesis by forming a ternary complex with GTP and initiator tRNA. This complex binds to a 40S ribosomal subunit, followed by mRNA binding to form a 43S preinitiation complex. Junction of the 60S ribosomal subunit to form the 80S initiation complex is preceded by hydrolysis of the GTP bound to eIF-2 and release of an eIF-2-GDP binary complex. In order for eIF-2 to recycle and catalyze another round of initiation, the GDP bound to eIF-2 must exchange with GTP by way of a reaction catalyzed by eIF-2B.
标记抗体
暂无标记数据
同靶标产品
暂无同靶标产品
相关文献
提示: 发表研究结果有使用 bsm-60003R 时请让我们知道,以便我们可以引用参考文章。作为回馈,资料提供者将获得我们送上的小礼品。
暂无相关文献
常见问题
暂无常见问题